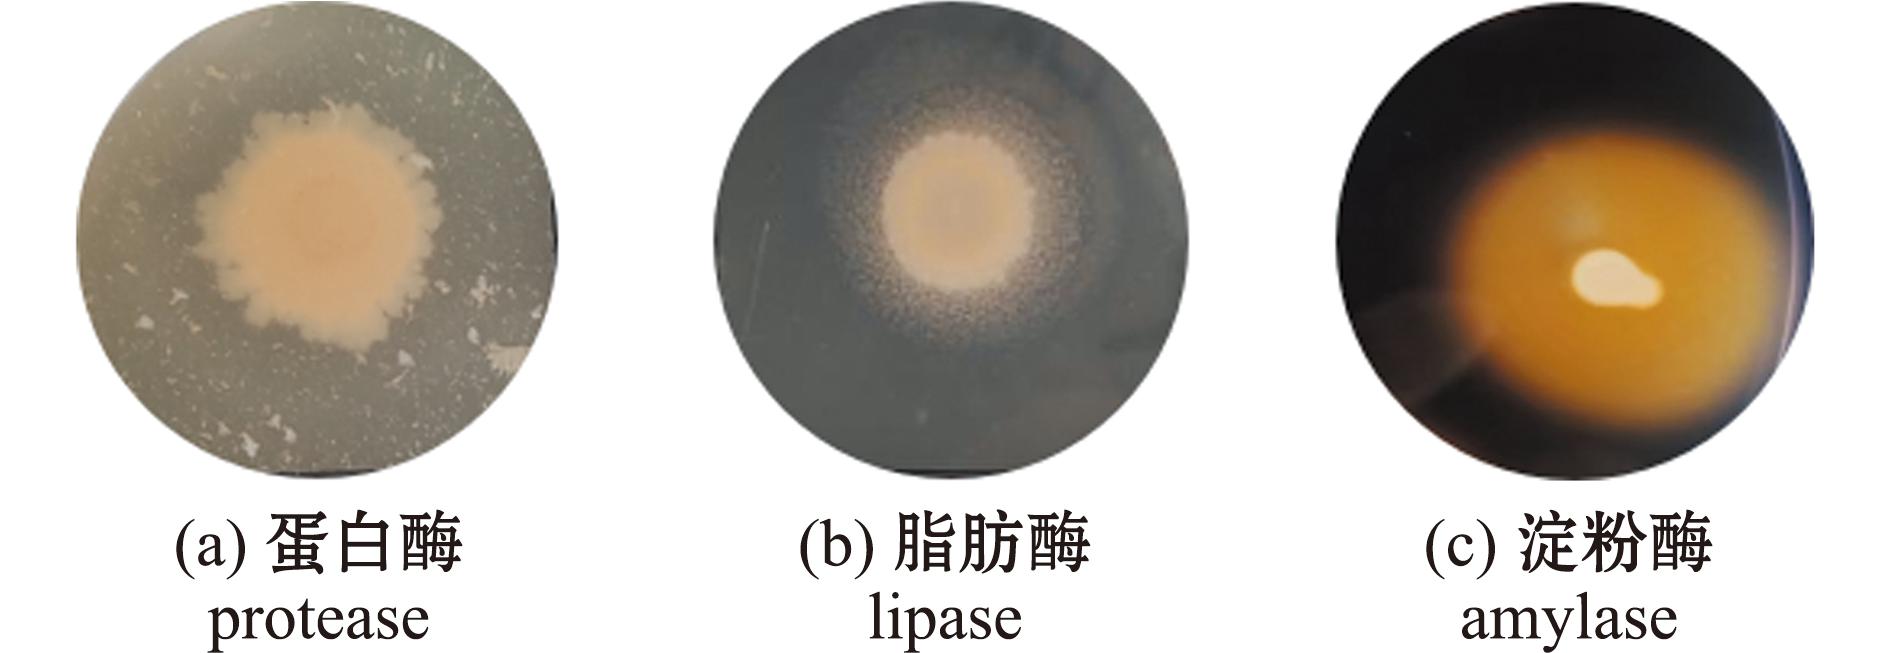

刺参(Apostichopus japonicus)隶属于棘皮动物门(Echinodermata)海参纲(Holothuroidea),是中国养殖的主要海参品种,具有较高的经济价值与营养价值[1-2],2023年中国海参养殖产量达29.2万t[3]。随着刺参养殖规模的扩大和养殖密度的增加,养殖水体水质不断恶化,刺参病害问题凸显[4],而全球气候变化、种质退化和病原区系特征变化等进一步加剧了病害的发生[5],对刺参养殖产业造成了严重的经济损失。当病害频发时,使用抗生素、消毒剂和微生态制剂等进行防治,已成为养殖者进行病害防控的重要手段,而抗生素的不规范使用不仅影响养殖水产品的质量和安全,还会引发水质恶化、药物残留、细菌耐药及微生态结构失衡[6],因此,开发一种生态高效、环境友好的刺参疾病控制方法至关重要。
益生菌不仅具有改善水质、抑制病原菌滋生及促进刺参免疫系统健康的作用,还能优化刺参肠道菌群结构[7]。近年来,益生菌在刺参的育苗、保苗及养殖过程中展现出显著的益生效果。研究表明,通过向养殖水体中添加益生菌,不仅能够有效改善水环境,还能显著促进刺参生长。源自宿主本身的益生菌,在早期发育阶段会迅速定植在宿主消化道[8],从而提高宿主生长性能,单一内源细菌枯草芽孢杆菌(Bacillus subtilis T13)[9]、马氏副球菌(Paracoccus marcusii DB11)[10]、叶氏假交替单胞菌(Pseudoalteromonas elyakovii HS1)[11]、希瓦氏菌(Shewanella sp.HS7)[11]和红酵母(Rhodotorula sp.C11)[12]等均可促进幼参生长。益生菌的作用机制之一是通过分泌多种消化酶,如蛋白酶、淀粉酶和脂肪酶等,高效水解饲料中的蛋白质、淀粉和脂肪等复杂有机物,释放出氨基酸、葡萄糖和脂肪酸等营养物质,从而促进水产养殖动物的消化与吸收;同时,通过占位效应抑制宿主肠道内致病菌的增殖,维护宿主肠道健康。赖凯昭等[13]对奥尼罗非鱼(Oreochromis niloticus♀×Oreochromis aureus♂)的研究发现,添加产酶益生菌能显著提高鱼的生长速率和蛋白酶活性。Bairagi等[14]在露斯塔野鲮(Labeo rohita)饲料中添加具有蛋白酶和淀粉酶活性的肠道益生菌后,鱼的生长性显著提升,食物转化率和蛋白质利用效率均有所提高,且未出现死亡或发病现象。以上研究结果表明,从健康动物体内分离的产酶益生菌具有高活性、良好适应性及宿主安全性,这为水产养殖中益生菌的筛选与应用提供了科学依据。
目前,刺参内源性益生菌在养殖中的应用仍然有限。本研究从健康刺参肠道分离可培养细菌,研究其产酶能力、溶血性、抗菌药物敏感性、对酸和胆盐的耐受性,以及对刺参的安全性及促生长作用,筛选具有潜在益生作用的菌株,以期深入了解益生菌在刺参养殖中的应用,为刺参养殖益生菌研发提供科学参考。
1 材料与方法
1.1 材料
刺参样品2023年9月6日购自辽宁省庄河市某养殖场,随机挑选3头健康刺参,体质量分别为126.3、145.5、105.3 g,取其肠道组织进行可培养细菌分离试验。
试验用2216E琼脂(HB0132)、2216E培养基(HB0132-1)购自青岛高科技工业园海博生物技术有限公司;PCR反应试剂盒为宝日医(TaKaRa)生物技术有限公司生产的TaKaRa PCR Amplification Kit (R011),PCR引物及测序引物使用通用引物27F(5′ AGAGTTTGATCMTGGCTCAG 3′)和1 492R(5′ TACGGYTACCTTGTTACGACTT 3′);革兰氏染色液试剂盒购自北京索莱宝(Solarbio)科技有限公司;蛋白酶测试盒、脂肪酶测试盒和淀粉酶测试盒购自苏州科铭生物技术有限公司;药敏纸片购自常德比克曼生物有限公司。
1.2 方法
1.2.1 刺参肠道可培养细菌的分离 从3只健康刺参中无菌取出肠道组织,经低温匀浆后用无菌海水梯度稀释至10-4、10-5、10-6,取0.1 mL稀释液均匀涂布于2216E琼脂平板,30 ℃下倒置培养24 h。挑选出形态不同的菌落进行连续划线培养,通过多次划线纯化获得单菌落,最终将纯化菌株冻存于-80 ℃冰箱中备用。
1.2.2 细菌溶血试验 将经过过夜培养于2216E培养基中的待测菌株点种于哥伦比亚血琼脂平板上。在30 ℃下倒置培养24 h,通过观察菌落周围是否形成透明圈来判断溶血素的产生。出现透明圈被认为是β溶血,出现绿色溶血环被认为是α溶血,未出现溶血区域的被认为是γ溶血,排除显示β溶血环的细菌,仅选择具有α或γ溶血的细菌[15]。
1.2.3 刺参肠道产酶细菌的筛选 试验用淀粉酶培养基的配制参照蔡红丹[16]的方法,脂肪酶培养基的配制参照罗璋[17]的方法,脱脂牛乳琼脂培养基的配制参照沈萍等[18]的方法,稍作修改。将活化后的菌株于30 ℃下以120 r/min摇床培养24 h,取2.5 μL菌液依次点种于淀粉酶琼脂板(含可溶性淀粉)、脂肪酶琼脂板(含Tween80)及脱脂牛乳琼脂板(含酪蛋白)表面,30 ℃下倒置培养48 h。使用卢哥氏碘液处理淀粉酶琼脂平板,菌落周围出现水解圈,说明菌株产淀粉酶;筛选培养基中添加脱脂牛乳,菌落周围出现透明圈,说明菌株产蛋白酶;以Tween80为底物,菌落周围出现沉淀环,说明菌株产脂肪酶。
1.2.4 细菌生长曲线 将-80 ℃冰箱冻存的菌株活化,参照沈萍[18]的方法进行测定,每株细菌设置3组平行。以取样时间为横坐标,以OD600 nm数值为纵坐标绘制细菌生长曲线。
1.2.5 分离菌株产酶能力的测定 将待测菌株接种于2216E液体培养基,在30 ℃下以120 r/min摇床中培养24 h,取1×104 CFU/mL浓度的菌液用于酶活力测定,使用蛋白酶测试盒、脂肪酶测试盒和淀粉酶测试盒进行测定。
1.2.6 药敏试验 采用常规纸片琼脂扩散(K-B)法,检测菌株对头孢氨苄、卡那霉素、复方新诺明等18种常用抗菌药物的敏感性,依据抑菌圈直径大小判定各菌株对药物的敏感性。具体方法:在无菌条件下,取100 μL培养至对数期的新鲜菌液,均匀涂布在2216E琼脂平板上,待琼脂培养基表面干燥后,将药敏纸片分别贴于琼脂培养基上,30 ℃下倒置培养24 h,参照(CLSI)2022版执行标准判定分离菌株对药物的敏感性[19]。
1.2.7 菌株耐酸耐胆盐试验
1)菌株耐酸能力试验根据郑秋霞等[20]的方法,将保存的菌株接入2216E液体培养基进行活化,将活化后的菌液以2%浓度接种于pH分别为3.0、4.0、5.0、6.0、7.0的2216E液体培养基中,在30 ℃下以120 r/min摇床中培养24 h。于24 h取样,测定每株菌种的OD600 nm值,并计算活菌数及其存活率(R,%),以pH 7.0为对照组,每组设置3个重复。若存活率超过100%,则表示该处理条件下未对分离株产生抑制效果。存活率计算公式为
R=A2/A0×100%。
(1)
式中:A2为24 h测定的每株菌在不同pH值时的活菌数;A0为24 h测定的每株菌在pH 7.0时的活菌数。
2)菌株耐胆盐能力试验参照Damayanti等[21]的方法,稍作修改。将菌株接入2216E液体培养基进行活化,将活化后的菌液以2%浓度接种于胆盐浓度为0.1%、0.3%、0.5%、0.7%的2216E液体培养基中,在30 ℃下以120 r/min摇床中培养24 h。于24 h取样,测定每株菌种的OD600 nm值,并计算活菌数及其存活率,将不添加胆盐的培养基作为对照组,每组设置3个重复。若存活率超过100%,则表示该处理条件下未对分离株产生抑制效果。存活率计算公式为
R=A3/A0×100%。
(2)
式中:A3为24 h测定的每株菌在不同胆盐浓度时的活菌数;A0为24 h测定的每株菌在不添加胆盐时的活菌数。
1.2.8 拟选菌株对刺参安全性评价 将体质量为(5±2)g的刺参置于盛有15 L过滤海水的22 L塑料桶中饲养,水温保持在(20±2)℃。在室内暂养1周后,将40只健康的刺参随机分为4组,每组10只。根据周慧慧等[22]的试验方法,将刺参设置为注射对照组、注射组、浸浴组和浸浴对照组,注射组注射0.1 mL浓度为1×108 CFU/mL的待测菌株的菌液,注射对照组注射等量的无菌海水;浸浴组投入菌悬液,使水体菌浓度达到108 CFU/mL,浸浴对照组不做处理,每天正常投喂基础饲料(大连庄河圣霖饲料)。饲料配方:大叶藻粉50%,海泥50%。试验期间,每天按刺参体质量的5%投喂,保持水温恒定,持续曝气并提供棉片附着,连续观察并记录刺参发病和死亡情况。
1.2.9 菌株形态学观察及16S rDNA序列进化分析
1)形态学观察。将所选菌株的单菌落挑取并接种于1 mL 2216E液体培养基中,于30 ℃下以120 r/min振荡培养至对数生长期。取适量菌液均匀涂布于洁净载玻片上,参照索莱宝革兰氏染色液说明书,依次进行固定、初染、媒染、脱色及复染处理。染色完成后,使用油镜进行显微观察,记录菌株的形态特征及染色结果。
2)细菌16S rDNA序列进化分析。基于菌株16S rDNA序列的BLASTn比对结果,筛选覆盖度高于91%、一致性大于99.7%且已鉴定至种水平的细菌,同时选取同源性较低的其他种属菌株作为对照。利用MEGA 7软件,采用Clustal W对16S rDNA序列进行多序列比对,随后通过邻位相接法(Neighbor-Joining)构建系统进化树,并设置自展检验(bootstrap)1 000次以评估进化树的可靠性。
1.2.10 刺参养殖试验 将大连市庄河市某养殖场的幼参(2.37±0.1)g分为两组,每组设置3个平行,饲养在盛有300 L过滤海水的总容量为330 L塑料桶中,共6桶,每桶幼参数量为100头,水温为(20±2)℃,一组幼参投喂日常饲料,另一组幼参施加潜在益生菌,根据菌株细胞浓度标准曲线定量移取菌液置于无菌离心管中,以6 000 g离心5 min后去上清,重悬于适量无菌海水中制备成菌悬液,将适量菌悬液加入水体中使菌株终浓度为1×106 CFU/mL[23-25]。养殖过程中,每日8:00投喂幼参总体质量5%的饲料,每10 d全量换水一次,并进行计数及称重,在换水前3 d对试验组重新添加菌液至终浓度为1×106 CFU/mL。养殖试验周期为60 d,观察刺参生长状态,试验结束后再次计数和称重,存活率(%)、体质量增加率(%)、特定生长率(%/d)、体质量变异系数(%)公式计算为
体质量增加率=(mt-m0)/m0×100%,
(3)
存活率=nt/n0×100%,
(4)
特定生长率=(lnmt-lnm0)/t×100%,
(5)
体质量变异系数=(S.D./X)×100%。
(6)
式中:n0为初始数量(ind.);nt为终末数量;m0为平均每只刺参初始体质量(g);mt为试验结束后平均每只刺参的体质量;t为试验时间(d);S.D.为标准差;X为刺参体质量平均值(g)。
1.3 数据处理
试验所有样品的测定均进行了3个平行组试验,试验数据以平均值±标准差(mean±S.D.)表示。试验数据采用SPSS 27.0软件进行单因素方差分析,采用Duncan法进行组间多重比较,采用Origin 2022软件绘图。
2 结果与分析
2.1 刺参肠道可培养细菌分离及产酶菌株筛选
2023年9月6日自庄河市养殖场采集刺参样品,解剖后取出肠道,经平板涂布和两次平板划线后,从肠道组织匀浆液中分离出30株细菌,对其进行溶血试验,结果表明,30株细菌均不产生β溶血环(图1)。

图1 溶血试验结果
Fig.1 Hemolytic test results
对这30株细菌进行产酶能力检测,结果见表1,13株产蛋白酶,19株产脂肪酶,10株产淀粉酶,3株未检测出产酶能力,其中仅有1株菌同时产3种酶,14株菌产两种酶,12株菌产1种酶,根据产酶能力选择产3种酶的菌株(记为AC27)进行后续试验,其产酶结果如图2所示。
表1 刺参肠道菌株的产酶能力
Tab.1 Enzyme production capacity of intestinal strains mimicking Apostichopus japonicus

菌株 strain蛋白酶 protease脂肪酶 lipase淀粉酶 amylaseAC1—+—AC2——+AC3—++AC4++—AC5—+—AC6++—AC7++—AC8++—AC9———AC10—+—AC11—+—AC12++—AC13—++AC14——+AC15———AC16—++AC17—+—AC18++—AC19———AC20+—+AC21—+—AC22+——AC23——+AC24++—AC25+——AC26—+—AC27+++AC28——+AC29+—+AC30++—
注:+表示有产酶能力;—表示无产酶能力。
Note:+means positive enzyme production;—means negative enzyme production.
图2 菌株AC27产酶结果
Fig.2 Results of enzyme production by strain AC27
2.2 细菌生长曲线
刺参肠道产酶菌株AC27在2216E液体培养基中30 ℃下以120 r/min摇床培养的生长曲线如图3所示。菌株AC27生长延滞期为0~16 h,培养24 h后进入对数生长期,培养48 h后进入稳定期,对数生长期菌液OD600 nm值为0.7~2.0。

图3 菌株AC27的生长曲线(30 ℃)
Fig.3 Growth curve of the strain AC27 (30 ℃)
2.3 菌株AC27的产酶活性测定
对产酶菌株所产蛋白酶、淀粉酶和脂肪酶的活性进行验证,结果见表2。菌株AC27所产酶的活性存在差异。其中,产蛋白酶活性最高,达到0.130 3 nmol/(min·104 cells);产淀粉酶活性次之,为0.084 6 nmol/(min·104 cells);产脂肪酶活性最低,仅为0.029 0 mg/(min·104 cells)。这表明,菌株AC27在产蛋白酶方面有优势,同时在产脂肪酶能力上相对较弱。
表2 菌株AC27产酶活性比较
Tab.2 Results of enzyme-producing activity of strain AC27

消化酶 digestive enzyme酶活性 enzyme activity蛋白酶 protease/[nmol·(min·104 cells-1)]0.130 3±0.006 4脂肪酶 lipase/[mg·(min·104 cells)-1]0.029 0±0.000 9淀粉酶 amylase/[nmol·(min·104 cells)-1]0.084 6±0.002 2
2.4 药敏试验
细菌耐药性是评估益生菌安全性的关键指标之一。本研究中,采用常用18种抗生素对产酶菌株AC27进行药敏试验,结果显示,菌株AC27对诺氟沙星表现为耐药,对卡那霉素、红霉素和多粘菌素B呈中度敏感,而对头孢氨苄、复方新诺明、氯霉素、四环素、阿奇霉素、克林霉素、利福平、呋喃唑酮、环丙沙星、万古霉素、链霉素、庆大霉素和新霉素均表现为高度敏感。综上所述,菌株AC27表现出有限的耐药性特征和较高的生物安全性,在刺参养殖中具有良好应用潜力(表3)。
表3 菌株AC27药敏试验结果
Tab.3 Antibiotics sensitivity test of strain AC27

注:—表示无抑菌圈;S表示高度敏感;I表示中度敏感;R表示耐药。
Note:—means no inhibition circle;S means highly sensitive;I means moderately sensitive;R means resistant.
2.4.1 菌株耐酸性 通过体外模拟试验评估菌株AC27的耐酸特性(图4)。结果显示:该菌株在不同pH环境中的存活率呈现显著的梯度变化,当环境pH值降至5.0和6.0时,其存活率分别下降至73.80%和5.25%;在pH 为3.0和4.0的极端酸性条件下,菌株AC27仍保持部分生物活性,存活率分别为0.4%和4.12%;所有酸性处理组的存活率与对照组均存在显著性差异(P<0.05)。这表明,菌株AC27具有显著的耐酸特性,在酸性环境能维持基础代谢活性,这为其作为潜在益生菌株在消化道中的定植能力提供了关键的试验依据。

标有不同字母者表示组间有显著性差异(P<0.05),标有相同字母者表示组间无显著性差异(P>0.05),下同。
The means with different letters are significantly different in the groups at the 0.05 probability level,and the means with the same letter are not significant differences,et sequentia.
图4 菌株AC27耐酸性试验结果
Fig.4 Acid resistance test of strain AC27
2.4.2 菌株耐胆盐性 在梯度胆盐胁迫培养24 h后,菌株AC27表现出显著的环境适应特征(图5),菌株AC27在胆盐浓度为0.1%时存活率为59.8%,在胆盐浓度为0.3%和0.5%时存活率明显受到抑制,存活率显著低于空白对照组(P<0.05),而在胆盐浓度为0.7%时存活率升高至121.0%。菌株AC27在胆盐浓度为0.1%~0.7%时均保持一定的存活能力,证实其对胆盐具有较高的耐受性。

图5 菌株AC27耐胆盐试验
Fig.5 Bile salt resistance test of strain AC27
2.5 安全性试验
基于菌株AC27的产酶能力、耐酸、耐胆盐特性及抗生素敏感性分析,菌株AC27具有潜在益生特性。为评估其安全性,对刺参进行攻毒试验,经过1周的观察,无论是通过腹腔注射细胞浓度为2.88×1010 CFU/g的AC27菌悬液,还是将其置于细胞浓度为1×108 CFU/mL的水体中进行浸浴,刺参均未出现发病或死亡现象。这表明,在试验所用的AC27菌液浓度下,菌株AC27对刺参无毒性,具备良好的生物安全性,可作为潜在益生菌进行后续开发研究。
2.6 菌株AC27形态学观察及16S rDNA序列分析
菌株AC27在2216E固体培养基上形成圆形菌落,表面光滑、隆起,呈乳白色不透明,边缘整齐。经革兰氏染色后,油镜观察显示细胞呈紫色,形态为短杆状,据此判定该菌株为革兰氏阳性杆菌(图6)。

图6 菌株AC27在显微镜下的形态
Fig.6 TMicroscopic morphology of strain AC27
试验中,采用通用引物27F和1492R对菌株AC27的16S rDNA进行PCR扩增,将测序结果通过BLASTn在NCBI数据库中进行相似性比对分析,并构建系统发育树(图7)。研究结果显示,菌株AC27与弯曲芽孢杆菌(Bacillus flexus)具有较高的同源性。在已鉴定至种水平的芽孢杆菌属细菌中,菌株AC27与Bacillus flexus strain DD10(MW575670.1)亲缘关系最近,其次为Priestiaflexa strain KSW-92(OR514189.1)和Bacillus flexus(MG020094.1)。

图7 基于16S rDNA序列构建的菌株AC27系统发育树
Fig.7 Phylogenetic tree of strain AC27 based on the sequences of 16S rDNA
结合菌株AC27的形态学观察结果与16S rDNA序列的系统发育分析,推断AC27属于芽孢杆菌属,且在已鉴定到种的该属细菌中,与Bacillus flexus strain DD10(MW575670.1)亲缘关系最为接近,同源性最高(一致性为100%)。
2.7 刺参养殖试验
菌株AC27对养殖刺参生长试验的影响结果见表4。经过60 d的浸浴试验,添加菌株AC27的试验组刺参体质量增加率为28.38%±10.00%,显著高于对照组15.13%±1.55%(P<0.05)。试验组刺参的特定生长率为0.43%±0.11%,较对照组0.23%±0.02%显著提高了86.96%(P<0.05)。在养殖试验期间,试验组刺参存活率为95.00%±1.00%,对照组存活率为96.33%±0.58%,两组间存活率无显著性差异(P>0.05)。初始对照组和试验组刺参的体质量变异系数分别为4.63%±0.20%和9.29%±0.85%,随着试验的进行,对照组刺参的体质量变异系数上升至5.45%±0.29%,试验组刺参的体质量变异系数降低至7.30%±0.51%。这表明,经菌株AC27浸浴处理显著提升了刺参的生长性能,并有效减小了个体间的差异性,提高了群体生长的整齐度。
表4 菌株AC27对刺参幼虫生长的影响
Tab.4 Effect of applying strain AC27 on the growth of larval Apostichopus japonicus

组别group初体质量/ginitial quality终体质量/gfinal quality体质量增加率/%WGR特定生长率/(%·d-1)SGR存活率/%SR初始体质量变异系数/%CV1终末体质量变异系数/%CV2对照组control group2.37±0.11a2.73±0.15a15.13±1.55a0.23±0.02a96.33±0.58a4.63±0.20a5.45±0.29a试验组test group2.28±0.21a2.95±0.21a28.38±10.00b0.43±0.11b95.00±1.00a9.29±0.85b7.30±0.51b
注:同列中标有不同字母者表示组间有显著性差异(P<0.05),标有相同字母者表示组间无显著性差异(P>0.05)。
Note:The means with different letters within the same column are significantly different in the groups at the 0.05 probability level,and the means with the same letter within the same column are not significant differences.
3 讨论
3.1 内源性益生菌的应用优势
目前,刺参养殖中使用的益生菌大多来自环境或陆生动物的肠道,忽略了物种、食性及水生环境特性等方面的差异。一方面,刺参为变温动物,而陆生动物为恒温动物;另一方面,陆生动物胃肠道结构及环境pH值与刺参有较大差别[26]。因此,陆源性刺参益生菌使用后多出现益生效果不明显或肠道定植失败等情况。而来自宿主肠道的细菌被认为是潜在益生菌的关键来源,其具备与肠道原生菌群竞争的能力,比非原生微生物更易定植且益生效果更持久[27]。Verschuere等[28]和Ninawe等[29]也认为,当益生菌来源于动物自身或其生长环境时,它们在水产养殖中的应用效果往往更为显著。因此,应用于刺参养殖的益生菌必须充分考虑其菌种的来源问题,而胃肠道和黏液层是刺参养殖中益生菌的主要分离来源[30-31]。Zhao等[32]从刺参肠道中分离出一株枯草芽孢杆菌,因其与本地环境的高度适应性,往往具备更强的竞争力,能有效对抗弧菌,并在肠道环境中占据主导地位。谢晓晨等[33]从菲律宾蛤仔的肠道中分离筛选出一株益生菌,结果表明其对蛤仔幼贝的生长具有促进作用。
为了避免益生菌应用时出现种属特异性,更好地发挥其促生长、抑制病原菌、提高免疫力等益生作用,本研究中从健康刺参肠道分离出产多种酶的细菌,通过产酶能力试验,以及耐强酸和胆盐能力试验,筛选出一株刺参肠道固有益生菌株—弯曲芽孢杆菌AC27,并应用于刺参的养殖试验,可望实现刺参益生菌的靶向定制,为刺参健康养殖提供更安全、更精准的解决方案。
3.2 弯曲芽孢杆菌菌株AC27对刺参的益生作用
现有研究表明,益生菌可产生多种消化酶,帮助宿主消化、吸收营养物质;部分细菌可通过增强免疫细胞及酶活性提高机体的非特异性免疫能力,从而促进宿主的生长[11]。周慧慧等[22]从刺参肠道分离得到的益生菌,有提高刺参幼虫对灿烂弧菌暴露的抗病性能力。Bao等[34]研究表明,施加多种益生菌有益于刺参的生长性能、先天免疫、肠道微生物生态及几种消化酶活性。田相利等[35]发现,投喂和泼洒芽孢杆菌BC-01可显著促进刺参的生长,并显著降低刺参体质量变异系数,从而降低刺参生长的个体分化。
本研究中从健康刺参肠道中分离得到一株具有产蛋白酶、脂肪酶、淀粉酶能力的弯曲芽孢杆菌AC27,通过高浓度的浸浴试验和注射试验,证明菌株AC27的安全性,并在养殖试验中通过浸浴菌株AC27后,发现其对刺参生长具有积极影响。 菌株AC27的使用有效促进了刺参的生长,AC27浸浴组刺参体质量增加率和特定生长率均显著高于对照组(P<0.05)。此外,浸浴菌株AC27的刺参体质量变异系数显著低于对照组。变异系数是反映数据在单位均值上的离散程度,数值越小表示刺参体质量相差越小,生长越整齐[36]。至试验结束时,试验组刺参体质量变异系数下降,对照组刺参体质量变异系数增加,说明使用菌株AC27可以减小不同个体体质量间的差异,提高刺参的整齐度,这对于刺参养殖生产具有重要的实践意义。
3.3 水产益生菌中的芽孢杆菌
本研究中分离出的菌株AC27鉴定为弯曲芽孢杆菌。各种芽孢杆菌作为水产益生菌已得到广泛应用,补充芽孢杆菌益生菌可以提高水生动物的应激耐受性、存活率、免疫反应和抗病性。Zhao等[9]研究表明,枯草芽孢杆菌可以直接增强刺参的非特异性免疫反应。Li等[37]发现,益生菌混合物中的枯草芽孢杆菌YB-1和蜡样芽孢杆菌YB-2能够通过调节肠道微生物群落和刺激先天免疫系统,促进海参的健康并提高其抗病能力。姜冰[38]从刺参养殖池塘沉积物中分离出两株芽孢杆菌B6和B7,可作为益生菌剂的基础菌株添加至刺参生长环境中,且对刺参的消化及免疫功能具有正向刺激作用。王金燕等[39]筛选的贝莱斯芽孢杆菌对刺参主要致病菌具有较好的拮抗作用,有助于降低池塘养殖刺参疾病的发生率,在水产养殖防控病害方面具有较大的应用潜力。
芽孢杆菌的促生长作用主要归因于其释放消化酶、产生维生素分解不可消化成分和上调生长相关基因表达的能力[40-41]。侯超等[42]在刺参的基础饲料中添加枯草芽孢杆菌微生态制剂后发现,刺参肠道内的酶活性均高于对照组,这表明饲料中添加微生态制剂有助于提升刺参的肠道酶活力。Zaineldin等[43]报道,无论益生菌浓度如何,益生菌的补充都会导致蛋白酶、脂肪酶和淀粉酶活性的增加。这些研究表明,许多具有产胞外酶能力的芽孢杆菌,如本研究中菌株AC27,可以有效提高宿主的生长性能。本研究中,养殖试验结束时菌株AC27补充组的刺参体质量增重率和特定生长率显著高于对照组,这与芽孢杆菌的益生特性研究结果一致,说明菌株AC27可作为研发刺参益生菌的菌种资源。因此,应进一步开展其在集约化养殖系统中的规模化应用验证及宿主肠道菌群调节机制研究,以推动其产业化进程。
4 结论
1)从健康刺参肠道中分离筛选得到1株产蛋白酶、淀粉酶和脂肪酶的细菌菌株AC27,经耐酸、耐胆盐试验、药敏试验和安全性试验发现,菌株AC27具有潜在的益生菌特性。
2)拟选菌株AC27为潜在益生菌株,经鉴定为弯曲芽孢杆菌。
3)刺参在菌株AC27浸浴浓度为106 CFU/mL的条件下,喂养60 d,试验组质量增加率和特定生长率均显著高于对照组,表明菌株AC27有促生长作用,可作为研发刺参益生菌的菌种资源。
[1] GUAN R W,PENG Y,ZHOU L T,et al.Precise structure and anticoagulant activity of fucosylated glycosaminoglycan from Apostichopus japonicus:analysis of its depolymerized fragments[J].Marine Drugs,2019,17(4):195.
[2] FENG Z F,SONG X J,ZHAO L T,et al.Isolation of probiotics and their effects on growth,antioxidant and non-specific immunity of sea cucumber Apostichopus japonicus[J].Fish &Shellfish Immunology,2020,106:1087-1094.
[3] 农业农村部渔业渔政管理局,全国水产技术推广总站,中国水产学会.2023中国渔业统计年鉴[M].北京:中国农业出版社,2023.Bureau of Fisheries,Ministry of Agriculture and Rural Affairs,National Fisheries Technology Extension Center,China Society of Fisheries.2023 China fishery statistical yearbook[M].Beijing: China Agriculture Press,2023.(in Chinese)
[4] CECCARELLI D,HASAN N A,HUQ A,et al.Distribution and dynamics of epidemic and pandemic Vibrio parahaemolyticus virulence factors[J].Frontiers in Cellular and Infection Microbiology,2013,3:97.
[5] 庞明海,王春元,王印庚,等.预防刺参腐皮综合征复方中药的筛选及体内药效评价[J].水生生物学报,2024,48(7):1130-1140. PANG M H,WANG C Y,WANG Y G,et al.Screening and evaluation of the in vivo pharmacological effects of traditional Chinese herbal formulas for the prevention of skin ulcer syndrome in sea cucumber Apostichopus japonicus[J].Acta Hydrobiologica Sinica,2024,48(7):1130-1140.(in Chinese)
[6] 闫倩倩,李彬,廖梅杰,等.山东主要刺参养殖区幼参肠道抗生素耐药菌及耐药基因分布特征[J].渔业科学进展,2020,41(4):134-143. YAN Q Q,LI B,LIAO M J,et al.Distribution characteristics of antibiotic resistant bacteria and antimicrobial resistant genes in the intestine of cultured sea cucumber(Apostichopus japonicus) seedlings in Shandong Province[J].Progress in Fishery Sciences,2020,41(4):134-143.(in Chinese)
[7] 赵瑞祯,张健.益生菌对刺参生长性能、肠道酶活性及抗氧化性能的影响[J].中国饲料,2021(20):61-64. ZHAO R Z,ZHANG J.Effects of probiotics on growth performance,intestinal enzyme activities and anti-oxidation of Stichopus japonicus[J].China Feed,2021(20):61-64.(in Chinese)
[8] SOLTANI M,GHOSH K,HOSEINIFAR S H,et al.Genus bacillus,promising probiotics in aquaculture:aquatic animal origin,bio-active components,bioremediation and efficacy in fish and shellfish[J].Reviews in Fisheries Science &Aquaculture,2019,27(3):331-379.
[9] ZHAO Y C,ZHANG W B,XU W,et al.Effects of potential probiotic Bacillus subtilis T13 on growth,immunity and disease resistance against Vibrio splendidus infection in juvenile sea cucumber Apostichopus japonicus[J].Fish &Shellfish Immunology,2012,32(5):750-755.
[10] YAN F J,TIAN X L,DONG S L,et al.Growth performance,immune response,and disease resistance against Vibrio splendidus infection in juvenile sea cucumber Apostichopus japonicus fed a supplementary diet of the potential probiotic Paracoccus marcusii DB11[J].Aquaculture,2014,420:105-111.
[11] CHI C,LIU J Y,FEI S Z,et al.Effect of intestinal autochthonous probiotics isolated from the gut of sea cucumber (Apostichopus japonicus) on immune response and growth of A. japonicus[J].Fish &Shellfish Immunology,2014,38(2):367-373.
[12] YANG Z P,SUN J M,XU Z.Beneficial effects of Rhodotorula sp.C11 on growth and disease resistance of juvenile Japanese spiky sea cucumber Apostichopus japonicus[J].Journal of Aquatic Animal Health,2015,27(2):71-76.
[13] 赖凯昭,吕逸欢,梁明振,等.饵料中添加益生菌对奥尼罗非鱼生长性能和肠道蛋白酶活性的影响[J].南方农业学报,2012,43(11):1769-1774. LAI K Z,LÜ Y H,LIANG M Z,et al.Tilapia growth and intestinal protease activity analysis after compound probiotics addition in diet[J].Journal of Southern Agriculture,2012,43(11):1769-1774.(in Chinese)
[14] BAIRAGI A,GHOSH K S,SEN S K,et al.Evaluation of the nutritive value of Leucaena leucocephala leaf meal,inoculated with fish intestinal bacteria Bacillus subtilis and Bacillus circulans in formulated diets for rohu,Labeo rohita (Hamilton) fingerlings[J].Aquaculture Research,2004,35(5):436-446.
[15] HALDER D,MANDAL M,CHATTERJEE S S,et al.Indigenous probiotic Lactobacillus isolates presenting antibiotic like activity against human pathogenic bacteria[J].Biomedicines,2017,5(2):31.
[16] 蔡红丹.石斑鱼肠道益生菌的筛选、鉴定及其益生效果研究[D].大庆:黑龙江八一农垦大学,2021. CAI H D.Screening identification and biotic effect of probiotics in the intestinal tract of grouper(Epinephelus coioides)[D].Daqing:Heilongjiang Bayi Agricultural University,2021.(in Chinese)
[17] 罗璋.斑点叉尾鮰肠道益生菌的筛选与特性研究[D].武汉:华中农业大学,2007. LUO Z.Selectoin and characteristics of probiotics from intestinal tract of Lctalurus punctatus[D].Wuhan:Huazhong Agricultural University,2007.(in Chinese)
[18] 沈萍,陈向东.微生物学实验[M].4版.北京:高等教育出版社,2007:188-189. SHEN P,CHEN X D.Microbiological experiment[M].4th ed.Beijing:Higher Education Press,2007:188-189.(in Chinese)
[19] CLSI.Performance standards for antimicrobial susceptibility testing.32nd ed.CLSI supplement M100[M].Wayne,PA:Clinical and Laboratory Standards Institute,2022.
[20] 郑秋霞,李自强,吴丽云.发酵蔬菜中乳酸菌分离及其耐酸耐胆盐特性分析[J].福建农业科技,2023,54(2):28-33. ZHENG Q X,LI Z Q,WU L Y.Isolation of lactic acid bacteria from fermented vegetables and analysis of its acid tolerance and bile salt tolerance characteristics[J].Fujian Agricultural Science and Technology,2023,54(2):28-33.(in Chinese)
[21] DAMAYANTI E,JULENDRA H,SOFYAN A,et al.Bile salt and acid tolerant of lactic acid bacteria isolated from proventriculus of broiler chicken[J].Media Peternakan,2014,37(2):80-86.
[22] 周慧慧,马洪明,张文兵,等.仿刺参肠道潜在益生菌对稚参生长、免疫及抗病力的影响[J].水产学报,2010,34(6):955-963. ZHOU H H,MA H M,ZHANG W B,et al.Effects of potential probiotics on growth performance and immune response of the juvenile sea cucumber (Apostichopus japonicus)[J].Journal of Fisheries of China,2010,34(6):955-963.(in Chinese)
[23] 杨宁,李金香,冷敦鹏,等.3种益生菌在不同浓度下对溶藻弧菌拮抗作用研究[J].山东畜牧兽医,2024,45(10):5-8. YANG N,LI J X,LENG D P,et al.Study on antagonistic effect of three probiotics on Vibrio alginolyticus at different concentrations[J].Shandong Journal of Animal Science and Veterinary Medicine,2024,45(10):5-8.(in Chinese)
[24] 李靖.养殖刺参早期发育阶段菌群结构演替及潜在益生菌的筛选[D].上海:上海海洋大学,2018. LI J.Succession of flora structure and screening of potential probiotics in the early development stage of cultured Stichopus japonicus[D].Shanghai:Shanghai Ocean University,2018.(in Chinese)
[25] FAR H Z,SAAD C R B,DAUD H M,et al.Effect of Bacillus subtilis on the growth and survival rate of shrimp (Litopenaeus vannamei)[J].African Journal of Biotechnology,2009,8(14).
[26] 徐振权,韩国威,任静,等.凡纳滨对虾肠道中地衣芽孢杆菌的分离鉴定及其生物学特性[J].大连海洋大学学报,2024,39(1):74-82. XU Z Q,HAN G W,REN J,et al.Isolation,identification and biological characteristics of Bacillus licheniformis from the intestine of Pacific white leg shrimp (Litopenaeus vannamei)[J].Journal of Dalian Ocean University,2024,39(1):74-82.(in Chinese)
[27] SERRA C R,ALMEIDA E M,GUERREIRO I,et al.Selection of carbohydrate-active probiotics from the gut of carnivorous fish fed plant-based diets[J].Scientific Reports,2019,9(1):6384.
[28] VERSCHUERE L,ROMBAUT G,SORGELOOS P,et al.Probiotic bacteria as biological control agents in aquaculture[J].Microbiology and Molecular Biology Reviews,2000,64(4):655-671.
[29] NINAWE A S,SELVIN J.Probiotics in shrimp aquaculture:avenues and challenges[J].Critical Reviews in Microbiology,2009,35(1):43-66.
[30] HAI N V.Research findings from the use of probiotics in Tilapia aquaculture:a review[J].Fish &Shellfish Immunology,2015,45(2):592-597.
[31] WU Z Q,JIANG C,LING F,et al.Effects of dietary supplementation of intestinal autochthonous bacteria on the innate immunity and disease resistance of grass carp (Ctenopharyngodon idellus)[J].Aquaculture,2015,438:105-114.
[32] ZHAO Y C,YUAN L,WAN J L,et al.Effects of a potential autochthonous probiotic Bacillus subtilis 2-1 on the growth and intestinal microbiota of juvenile sea cucumber,Apostichopus japonicus selenka[J].Journal of Ocean University of China,2018,17(2):363-370.
[33] 谢晓晨,王博,姜嘉琳,等.一株菲律宾蛤仔肠道潜在益生菌的分离鉴定及其应用效果分析[J].大连海洋大学学报,2024,39(4):568-577. XIE X C,WANG B,JIANG J L,et al.Isolation and application of a bacterial strain with potential probiotic effects from intestinal tract of Manila clam (Ruditapes philippinarum)[J].Journal of Dalian Ocean University,2024,39(4):568-577.(in Chinese)
[34] BAO N,REN T J,HAN Y Z,et al.Alteration of growth,intestinal Lactobacillus,selected immune and digestive enzyme activities in juvenile sea cucumber Apostichopus japonicus,fed dietary multiple probiotics[J].Aquaculture International,2017,25(5):1721-1731.
[35] 田相利,赵坤,王军,等.泼洒和投喂芽孢杆菌对刺参生长以及消化和免疫相关酶活性的影响[J].中国海洋大学学报(自然科学版),2015,45(1):18-25. TIAN X L,ZHAO K,WANG J,et al.Influence of water additive and feed supplementary Bacillus cereus on the growth and activity of digestive and immune relating enzyme of sea cucumber[J].Periodical of Ocean University of China(Natural Science Edition),2015,45(1):18-25.(in Chinese)
[36] 梁淼.刺参(Apostichopus japonicus)个体生长差异的实验研究[D].青岛:中国海洋大学,2010. LIANG M.Experimental studies on individual variation in growth and causes in sea cucumber,Apostichopus japonicus[D].Qingdao:Ocean University of China,2010.(in Chinese)
[37] LI J G,XU Y P,JIN L J,et al.Effects of a probiotic mixture (Bacillus subtilis YB-1 and Bacillus cereus YB-2) on disease resistance and non-specific immunity of sea cucumber,Apostichopus japonicus (Selenka)[J].Aquaculture Research,2015,46(12):3008-3019.
[38] 姜冰.两株芽孢杆菌的生长特性及其对仿刺参的益生作用[J].河北渔业,2017(2):1-5. JIANG B.Growth characteristics of two Bacillus strain and its probiotic effects on sea cucumber Apostichopus japonicus[J].Hebei Fisheries,2017(2):1-5.(in Chinese)
[39] 王金燕,李彬,王印庚,等.刺参养殖池塘一株贝莱斯芽孢杆菌的分离及其生理特性[J].中国水产科学,2018,25(3):567-575. WANG J Y,LI B,WANG Y G,et al.Screening and characteristic analysis of Bacillus velezensis from sea cucumber(Apostichopus japonicus) ponds[J].Journal of Fishery Sciences of China,2018,25(3):567-575.(in Chinese)
[40] HOSEINIFAR S H,ROOSTA Z,HAJIMORADLOO A,et al.The effects of Lactobacillus acidophilus as feed supplement on skin mucosal immune parameters,intestinal microbiota,stress resistance and growth performance of black swordtail (Xiphophorus helleri)[J].Fish &Shellfish Immunology,2015,42(2):533-538.
[41] EISSA N.Effect of probiotic on growth performance and growth-regulated genes in yellow perch (Perca flavescens)[J].Global Journal of Fisheries and Aquaculture Researches,2014,1(2):1-15.
[42] 侯超,钱斯日古楞,王红英,等.枯草芽孢杆菌微生态制剂制备及在仿刺参养殖中的应用[J].工业微生物,2014,44(5):14-18. HOU C,QIAN S R G L,WANG H Y,et al.Preparation of Bacillus subtilis microbial ecological agent and its application to sea cucumber culture[J].Industrial Microbiology,2014,44(5):14-18.(in Chinese)
[43] ZAINELDIN A I,HEGAZI S,KOSHIO S,et al.Bacillus subtilis as probiotic candidate for red sea bream:growth performance,oxidative status,and immune response traits[J].Fish &Shellfish Immunology,2018,79:303-312.